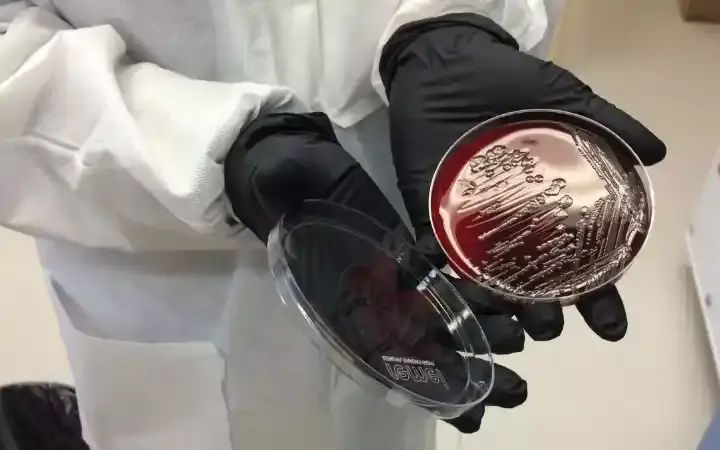

اللطف فضيلة، ومع ذلك، فإن بعضًا من ألطف الأشخاص لا يملكون دائرة أصدقاء واسعة. إنها مفارقة حيرت الناس لفترة طويلة. يُظهر هؤلاء الأشخاص الطيبون للغاية تسعة سلوكيات شائعة
عرض النقاط الرئيسية
غالبًا ما يكون لدى الأشخاص الطيبين منظور مختلف للعلاقات. فهم يُقدّرون العلاقات العميقة والهادفة على العلاقات السطحية. إنهم من النوع الذي يُفضل أن يكون لديه عدد قليل من الأصدقاء المقربين الذين يثقون بهم ويعتمدون عليهم، بدلًا من دائرة كبيرة من المعارف. غالبًا ما يكون الأشخاص الطيبون متعاطفين وحساسين. يُعطون الكثير في علاقاتهم، ويحتاجون إلى التأكد من أن الأشخاص الذين يُعطونهم يستحقون طاقتهم ووقتهم. إنهم ليسوا انطوائيين، بل يُفضلون الاستثمار في صداقات عالية الجودة وذات معنى ومُجزية.
قراءة مقترحة
قد يكون سوء الفهم عقبة شائعة أمام الأشخاص الطيبين عند تكوين الصداقات. فليس الأمر أنهم لا يستطيعون تكوين صداقات؛ بل إن لطفهم قد يُساء تفسيره أحيانًا، مما يدفعهم إلى توخي الحذر بشأن من يسمحون لهم بدخول حياتهم.
غالبًا ما يكون الأشخاص الطيبون عميقي التأمل وعميقي التفكير. ونتيجةً لذلك، قد يستغرقون وقتًا أطول للانفتاح ومشاركة عالمهم الداخلي مع الآخرين. هذا ليس لأنهم كتومون أو منغلقون؛ بل هو انعكاس لوعيهم الذاتي العميق وطريقة تفكيرهم الدقيقة. إذ يميل الأشخاص الأكثر انطوائية إلى تكوين صداقات أقل ولكنها أعمق. تذكر أن كل شخص يعمل وفقًا لجدوله الزمني الخاص عندما يتعلق الأمر بتكوين العلاقات. بالنسبة للأفراد الطيبين، قد يستغرق الأمر وقتًا أطول قليلاً لبناء تلك الروابط.
الأشخاص الطيبون، . يمكنهم حب الآخرين والاهتمام بهم بعمق، لكنهم يدركون أيضًا أهمية التخلي عن العلاقات وعدم التعلق بها. إن ممارسة التجرد تؤدي إلى حياة أكثر إشباعًا وسلامًا. ومع أن هذا النهج قد يُقلص دائرتهم الاجتماعية، إلا أنه يعني أيضًا خلو علاقاتهم من التبعية غير الصحية وحب التملك. هذه العقلية تُمكّن الأفراد الطيبين من تكوين صداقات قائمة على الاحترام المتبادل والتفاهم، بدلًا من الشعور بالحاجة أو الخوف.
إنهم لا يمانعون قضاء الوقت بمفردهم، بل قد يجدونه منعشًا. إن الشعور بالراحة مع العزلة تُتيح لهم استعادة نشاطهم، والتأمل، والوعي. خلال هذه الأوقات الهادئة من التأمل الذاتي، يمكنهم الاستفادة من لطفهم وتعاطفهم بشكل أكبر. ومع ذلك، قد يُساء تفسير هذه الراحة في العزلة أحيانًا من قِبل الآخرين على أنها عدم اهتمام بالتواصل الاجتماعي أو تكوين الصداقات. في الواقع، إنها ببساطة طريقتهم للحفاظ على التوازن والوفاء لأنفسهم.
إن الأشخاص الطيبين غالبًا ما يبذلون قصارى جهدهم لمساعدة الآخرين، إلا أنهم يدركون أيضًا أهمية وضع الحدود. إذ يدرك الأشخاص الطيبون تمامًا احتياجاتهم ومشاعرهم، ويحترمون أنفسهم بما يكفي للتعبير عن هذه الاحتياجات للآخرين. وفي حين أن وضع الحدود قد يؤدي إلى صداقات أقل، فإن العلاقات التي يحافظون عليها تكون أكثر صحة وتوازنًا. بدلاً من تشتيت أنفسهم لإرضاء الجميع، يركزون على بناء علاقات تحترم حدودهم وتُقدّر لطفهم.
غالبًا ما يكون الأشخاص الطيبون حساسين للغاية ومتعاطفين. يشعرون بالأشياء بعمق ويمكنهم بسهولة استشعار مشاعر من حولهم. وبينما تُعدّ هذه سمة جميلة، إلا أنها تعني أيضًا ضرورة اختيارهم لطاقاتهم. فقد يختارون قضاء الوقت مع أشخاص يُلهمونهم ويُعززون معنوياتهم، بدلًا من أولئك الذين يُستنزفون طاقتهم أو يُؤثرون عليها سلبًا. غالبًا ما تُؤدي هذه الانتقائية إلى تضييق دائرة علاقاتهم الاجتماعية، لكنها تضمن أيضًا أن تكون تفاعلاتهم مُثرية وإيجابية. والأمر لا يتعلق بالحصرية؛ بل بحماية طاقتهم والحفاظ على سلامتهم العاطفية. ففي النهاية، يدركون أنهم قادرون على تقديم أفضل خدمة للآخرين عندما يكونون في حالة إيجابية ومتوازنة.
إنهم صادقون مع أنفسهم ولا يخشون إظهار حقيقتهم للعالم. فهم لا يهتمون بالتظاهر أو التظاهر بأنهم شخص آخر لمجرد التأقلم. بدلاً من ذلك، يختارون أن يكونوا صادقين ويعبرون عن مشاعرهم وأفكارهم الحقيقية. وفي حين أن هذه الأصالة قد تجعل من الصعب عليهم الاندماج في الحشد، إلا أنها تجذب أيضًا النوع المناسب من الأشخاص تجاههم - أولئك الذين يقدرون أصالتهم ويثمنونها. ففي حين أنه قد لا يكون لديهم مجموعة كبيرة من الأصدقاء، فمن المرجح أن يكون أصدقاؤهم صادقين وداعمين ومقدرين لأصالتهم.
ربما يكون أهم سلوك يجب فهمه عن الأشخاص الطيبين هو أنهم لا يقيسون قيمتهم الذاتية بناءً على عدد أصدقائهم. إنهم يدركون أن وجود الكثير من الأصدقاء لا يعني بالضرورة أن هذه الصداقات مُرضية أو ذات معنى. إذ لا يرتبط تقديرهم لذاتهم بالقبول الاجتماعي؛ بل إنها متجذرة في قيمهم وأفعالهم واللطف الذي يُظهرونه للآخرين. فهم لا يحتاجون إلى تأييد من دائرة اجتماعية واسعة ليشعروا بالرضا عن أنفسهم. وهذا المنظور يُمكّنهم من التركيز على رعاية علاقات وثيقة وذات معنى بدلاً من محاولة كسب استحسان الكثيرين. إنها صفةٌ تُبرز بوضوح قوة شخصيتهم وفهمهم العميق لما هو مهم حقًا في الحياة.
عندما نتحدث عن السلوك البشري والصداقات، فإن ما يهم حقًا هو عمق وجودة هذه العلاقات، وليس كميتها. غالبًا ما يكون للأشخاص الطيبين، كما ذكرنا، دوائر اجتماعية أصغر. لكن تذكروا، هذا لا يعني أنهم وحيدون أو يفتقرون إلى الرفقة. بل على العكس، غالبًا ما تكون صداقاتهم أعمق وأكثر معنى. وهم يختارون تركيز طاقتهم على رعاية هذه العلاقات وتقديم أقصى درجات الرعاية والتعاطف. إنهم يُدركون القيمة العميقة للعلاقات الأصيلة القائمة على الثقة على الصداقات السطحية. لذا، إذا وجدت نفسك أو شخصًا تعرفه يتبنى هذه السلوكيات، فلا داعي للقلق. الأمر لا يتعلق بكثرة الأصدقاء؛ بل باختيار الأصدقاء المناسبين. الأمر يتعلق بتكوين روابط تُثري حياتك، وتوفر الدعم المتبادل، وتعزز نموك الشخصي. في نهاية المطاف، في رحلة الحياة، ليس عدد الرفاق هو المهم، بل جودة الرفقة.
5 تتبيلات للاسماك من المطابخ العربية
قرية تينمل ومسجدها القروي في المغرب : رحلة عبر الزمن
منطقة حائل في السعودية تكشف عن 23 فرصة استثمارية لتحفيز النمو الاقتصادي
أغرب نظرية على الإطلاق عن توابيت السرابيوم الغامضة في مصر
هل يمكننا أن نشعل شرارة "العصر الذهبي" الجديد للمضادات الحيوية؟
كتب علمية جذابة للقراءة قد تغير حياة الإنسان إلى الأبد
قد تكون النار هي الظاهرة الطبيعية الأندر في الكون
6 فواكه فوائد لم تعرفها من قبل
كيف سيؤثر تغير المناخ على إنتاج المحاصيل في المستقبل؟
ماذا حدث للأعلام التي تركها رواد الفضاء على القمر منذ حوالي نصف قرن؟